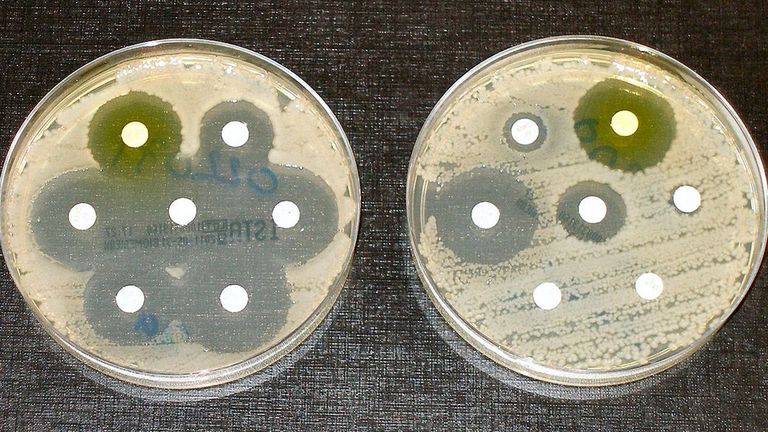
بعض أنواع البكتيريا تستعيد نشاطها بعد انتهاء جرعات المضادات الحيوية

بكتيريا تخدع المضادات الحيوية.. تهديد "خفي" يطارد البشرية
هل أصبت من قبل بعدوى سيئة لكنك كلما قضيت عليها عادت مرة أخرى بنفس الأعراض؟
سبب عودة سيلان الأنف، أو الكحة، أو أعراض البرد بعد مدة وجيزة مرة أخرى، ربما يكون بسبب تعاملك مع بكتيريا تتحمل المضادات الحيوية، وتقاومها.
تعد مقاومة المضادات الحيوية مشكلة كبيرة، حيث ساهمت في وفاة ما يقرب من 1.27 مليون شخص في جميع أنحاء العالم في عام 2019، بحسب "ScienceAlert".
يعتبر تحمُّل المضادات الحيوية تهديدًا خفيًّا بدأ الباحثون في استكشافه مؤخرًا فقط، حيث انشغلوا في السابق بدراسة مقاومة البكتيريا للمضادات الحيوية.
ويحدث تحمل المضادات الحيوية عندما تتمكن البكتيريا من البقاء على قيد الحياة لفترة طويلة بعد تعرضها لمضاد حيوي.
في حين أن البكتيريا المقاومة للمضادات الحيوية تزدهر حتى في وجود مضاد حيوي، غالبًا ما توجد البكتيريا التي تتحمل المضادات في حالة كمون، لا تنمو ولا تموت ولكن تتعايش مع المضاد الحيوي حتى تتمكن من "الاستيقاظ" بمجرد زوال جرعات المضاد.
الكوليرا وتحمل المضادات الحيوية
تم تصميم العديد من المضادات الحيوية لاختراق الدفاعات الخارجية للبكتيريا مثل كرة المدفع التي تخترق حصنا حجريا.
البكتيريا المقاومة محصنة ضد قذيفة المدفع لأنها يمكن أن تدمرها قبل أن تدمر جدارها الخارجي أو تغير جدرانها لتكون قادرة على تحمل التأثير.
أما البكتيريا المتحملة فيمكنها إزالة جدارها بالكامل وتجنب الضرر تمامًا، وعندما يختفي تهديد المضادات الحيوية، تقوم البكتيريا بإعادة بناء جدارها لحمايته من الأخطار البيئية الأخرى واستئناف الوظائف الطبيعية.
ومع ذلك، لا يزال من غير المعروف كيف تعرف البكتيريا زوال تهديد المضادات الحيوية، وما الذي يؤدي بالضبط إلى استيقاظها من جديد.
يحاول مجموعة من الباحثين في مختبر دور بجامعة كورنيل فهم عمليات التنشيط وإعادة الاستيقاظ في البكتيريا المسؤولة عن الكوليرا بعد تطور مقاومة البكتيريا الضمة بسرعة ضد أنواع مختلفة من المضادات الحيوية، مما أثار قلق الأطباء.
اعتبارًا من عام 2010، أصبحت البكتيريا الضمة مقاومة بالفعل لـ 36 مضادًا حيويًا مختلفًا، ومن المتوقع أن يستمر هذا العدد في الارتفاع.
لدراسة كيفية تطوير البكتيريا الضمة للمقاومة، اختار الباحثون سلالة تتحمل فئة من المضادات الحيوية تسمى بيتا لاكتام Beta-lactams، ووجد العلماء أن البكتيريا الضمة تتكيف مع المضادات الحيوية عن طريق تنشيط اثنين من الجينات التي تزيل جدارها الخلوي مؤقتًا.
بعد إزالة جدار الخلية، تقوم البكتيريا بتنشيط المزيد من الجينات التي تحولها إلى كرات هشة يمكنها البقاء على قيد الحياة من آثار المضاد الحيوي.
وبمجرد إزالة المضاد الحيوي أو تحلله، تعود البكتيريا الضمة إلى شكلها الطبيعي وتستمر في النمو.
عند الأشخاص، تُرى عملية التحمل هذه عندما يصف الطبيب مضادًا حيويًا، عادةً دوكسيسيكلين، لمريض مصاب بالكوليرا. فيوقف المضاد الحيوي العدوى مؤقتًا، ولكن بعد ذلك تبدأ الأعراض في الظهور مرة أخرى لأن المضادات الحيوية لم تزل البكتيريا تمامًا في المقام الأول.
إن القدرة على العودة إلى طبيعتها والنمو بعد زوال المضاد الحيوي هي مفتاح البقاء على قيد الحياة. إن تعريض البكتريا الضمة لمضاد حيوي لفترة طويلة بما يكفي من شأنه أن يقتلها في النهاية، لكن العلاج القياسي للمضادات الحيوية غالبًا لا يكون طويلًا بما يكفي للتخلص من جميع البكتيريا حتى في حالتها الهشة.
ومع ذلك، فإن تناول الدواء لفترة طويلة يمكن أن يضر البكتيريا والخلايا السليمة، مما يتسبب في تعب المرض، وبالإضافة إلى ذلك، يمكن أن يؤدي سوء الاستخدام والتعرض المطول للمضادات الحيوية إلى زيادة فرص مقاومة البكتيريا الأخرى الموجودة في الجسم.
البكتيريا الأخرى تطور التحمل
البكتريا الضمة ليست النوع الوحيد الذي يظهر التحمل، حيث حدد الباحثون مؤخرًا العديد من البكتيريا المعدية التي طورت القدرة على التحمل: عائلة بكتيريا تسمى Enterobacteriaceae، والتي تشمل مسببات الأمراض الرئيسية التي تنقلها الأغذية السالمونيلا، والشيغيلا، والإي كولاي، وهي ليست سوى عدد قليل من الأنواع العديدة من البكتيريا القادرة على تحمل المضادات الحيوية.
ما تم اكتشاف أن عملية التمثيل الغذائي للبكتيريا، أو الطريقة التي تكسر بها "الطعام" لإنتاج الطاقة، قد تلعب دورًا مهمًا في قدرتها على التحمل.
تتكون الهياكل المختلفة داخل البكتيريا، بما في ذلك جدارها الخارجي، من لبنات بناء معينة مثل البروتينات.
يؤدي إيقاف قدرة البكتيريا على صنع هذه القطع إلى إضعاف جدارها، مما يزيد من احتمالية تعرضها للضرر من البيئة الخارجية قبل أن تتمكن من تدمير الجدار.

التحمل والمقاومة
على الرغم من وجود أبحاث كثيرة حول كيفية تطور البكتيريا للتحمل، إلا أن جزءًا رئيسيًا من اللغز الذي تم إهماله هو كيف يؤدي التحمل إلى المقاومة.
في عام 2016، اكتشف الباحثون كيفية جعل البكتيريا تتحمل المضادات في المختبر، بعد التعرض المتكرر لمضادات حيوية مختلفة، حيث تمكنت خلايا الإشريكية القولونية من التكيف والبقاء على قيد الحياة.
عندما يتلف الحمض النووي بسرعة بسبب الإجهاد، مثل التعرض للمضادات الحيوية، فإن آليات إصلاح الخلية تميل إلى التسبب في حدوث طفرات يمكن أن تخلق المقاومة والتحمل.
نظرًا لأن الإشريكية القولونية تشبه العديد من الأنواع المختلفة من البكتيريا، فقد كشفت نتائج الباحثين أنه يمكن لأي بكتيريا بشكل أساسي تطوير التحمل إذا تم دفعها إلى أقصى حدودها بواسطة المضادات الحيوية التي تهدف إلى قتلها.
كان الاكتشاف الرئيسي الأخير هو أنه كلما طالت مدة قدرة البكتيريا على التحمل، زادت احتمالية تطويرها للطفرات التي تؤدي إلى المقاومة.
يسمح التحمل للبكتيريا بتطوير طفرة مقاومة تقلل من فرص قتلها أثناء العلاج بالمضادات الحيوية، وهذا مهم بشكل خاص للمجتمعات البكتيرية التي تظهر غالبًا في الأغشية الحيوية التي تميل إلى تغطية الأسطح عالية اللمس في المستشفيات.
الأغشية الحيوية عبارة عن طبقات لزجة من البكتيريا تفرز هلامًا واقيًا مما يجعل العلاج بالمضادات الحيوية أمرًا صعبًا ومشاركة الحمض النووي بين الميكروبات أمرًا سهلاً، حيث يمكنهم حث البكتيريا على تطوير المقاومة.
يُعتقد أن هذه الظروف تحاكي ما يمكن أن يحدث أثناء معالجة العدوى بالمضادات الحيوية، حيث تعيش العديد من البكتيريا جنبًا إلى جنب وتتشارك الحمض النووي.
يدعو الباحثون إلى مزيد من البحث في تحمل المضادات الحيوية على أمل أن يؤدي ذلك إلى علاجات أكثر قوة في كل من الأمراض المعدية والسرطانات.
وهناك سبب يدعو للتفاؤل. في أحد التطورات الواعدة، حيث وجدت دراسة على الفئران أن تقليل التحمل يقلل أيضًا من المقاومة.
وفي الوقت نفسه، هناك خطوات يمكن للجميع اتخاذها للمساعدة في المعركة ضد تحمل المضادات الحيوية ومقاومتها، حيث يمكنك القيام بذلك عن طريق تناول المضاد الحيوي تمامًا كما هو موصوف من قبل الطبيب وإنهاء الزجاجة بالكامل، وعدم تكراره دون وصف الطبيب.
إن التعرض القصير وغير المتسق للدواء يهيئ البكتيريا لتصبح قادرة على التحمل ومقاومة في نهاية المطاف، ويمكن أن يوقف الاستخدام الأكثر ذكاءً للمضادات الحيوية من قبل الجميع تطور البكتيريا المتحملة.